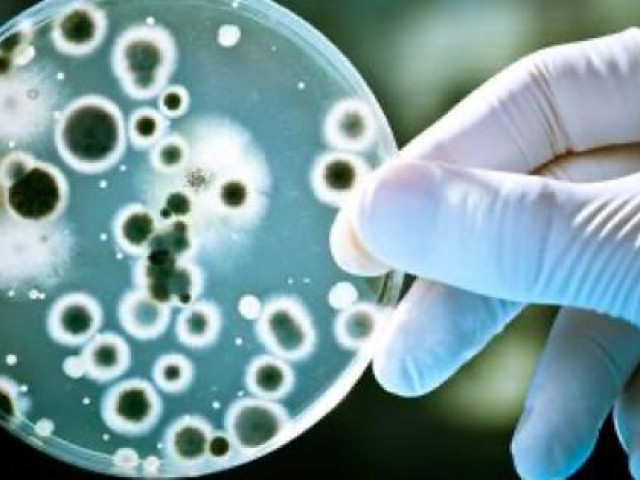
Thế giới - Trí tuệ nhân tạo tìm ra thuốc kháng sinh “kỳ diệu” chưa từng có

Cuộc chạy đua trở thành siêu cường AI toàn cầu của Trung Quốc
Trung Quốc muốn dẫn đầu thế giới về trí tuệ nhân tạo (AI) cho đến cuối thập kỷ này. Nhưng các trừng phạt thương mại từ phía Mỹ đã tác động không nhỏ đến nhập khẩu công nghệ và “chảy máu chất xám” các kỹ sư tài ba nhất cũng sẽ không dễ dàng đạt được tham vọng đó.
Tác giả bài viết, bà Gabrielle Chou, người có học vị tiến sĩ về luật sở hữu trí tuệ của Đại học Paris, và thạc sĩ Luật của Đại học London (Đại học Queen Mary). Năm 2021, bà Gabrielle có học vị giáo sư, và bắt đầu giảng dạy công nghệ tại Đại học New York Thượng Hải, bà cũng có 25 năm sinh sống tại thành phố này.
Vào tháng 10/2017, Hội đồng nhà nước Cộng hòa nhân dân Trung Hoa (PRC – cơ quan hành chính tối cao của nước này) đã chỉ định trí tuệ nhân tạo (AI) là “ưu tiên quốc gia”, khái quát rõ tham vọng trở thành “trung tâm đổi mới AI hàng đầu thế giới” vào thời điểm năm 2030. Đây quả là ván cược cao vì AI của Trung Quốc dựa trên các ứng dụng y học, công nghiệp và vận tải, mà cụ thể là những phương tiện tự trị, cũng như có khả năng trở thành động lực chính cho sự tăng trưởng đất nước. Ngoài những biểu hiện đơn thuần về ý chí chính trị, Trung Quốc chắc chắn đã có những lợi thế nhất định. Người tiêu dùng Trung Quốc là những người xài điện thoại thông minh (ĐTTM) lớn nhất thế giới trong việc thanh toán hàng hóa và dịch vụ, phần mềm nhận dạng giọng nói, cũng như trợ lý ảo.
Máy phục vụ thức ăn tại nhà hàng ở Quảng Châu, tỉnh Quảng Đông, ngày 22 tháng 9 năm 2022. Ảnh nguồn: Stringer - Anadolu - Getty.
Dân Trung Quốc đã chấp nhận một thực tế rộng rãi rằng người máy đang giải quyết tình trạng thiếu hụt lao động trong khách sạn, bệnh viện và ngân hàng, việc bắt gặp cảnh người máy giao hàng hoặc người máy làm lễ tân ở các khách sạn không phải là chuyện hiếm gặp ở quốc gia này ngày nay. Ngoài ra, người máy còn đảm nhiệm nhiều vai trò tại các công trường xây dựng, khai khoáng và thậm chí cả cứu trợ thiên tai. Năm 2021, với 800 triệu người dùng ĐTTM trong tổng dân số 1,4 tỷ người, Trung Quốc đã tạo ra một lượng lớn thông tin kỹ thuật số, có thể truy cập rộng rãi các quy định trong khi chúng vẫn bảo vệ dữ liệu người tiêu dùng (thường được nới lỏng trong các trường hợp “lợi ích quốc gia” trong lĩnh vực y tế chẳng hạn). Thêm nữa còn có những chế độ quản lý đặc biệt đối với công nghệ sinh học, kỹ thuật sinh học và dược phẩm sinh học nhằm khuyến khích sự phối hợp giữa các công ty, các nhà nghiên cứu và chính quyền các địa phương.
Chính sự liên kết chặt chẽ này đã thu hút các nhà đầu tư: vài đột phá công nghệ sinh học lớn đã ra lò, chẳng hạn như xử lý ngôn ngữ tự nhiên tự động và máy học để thu thập và phân tích dữ liệu y khoa nhằm dự đoán các kết quả thử nghiệm lâm sàng, và tối ưu hóa thiết kế nghiên cứu lâm sàng. Trung Quốc cũng có một lượng lớn công nhân lành nghề: khoảng 1,4 triệu kỹ sư đủ tiêu chuẩn hàng năm tức gấp 6 lần so với Mỹ và ít nhất 1/3 trong số họ là kỹ sư về AI.
Trong lĩnh vực an ninh mạng của Trung Quốc nơi có 4 đại công ty gồm Bairong, TransInfoTech, Dahua Technology và Hikvision. Cũng như SenseTime đang sẵn sàng chiếm thị phần lớn nhất trong thị trường nội địa cho các công ty công nghệ AI sử dụng thị giác máy tính. SenseTime vốn đã chiếm ưu thế trong an ninh nhận dạng khuôn mặt thì giờ đây họ đang áp dụng chuyên môn trong những lĩnh vực khác. Chẳng hạn như hãng này đã phát triển ra loại phần mềm có thể nhận dạng khuôn mặt, ước tính tuổi tác và đối chiếu chéo chúng với dữ liệu thương mại nhằm giúp các nhà bán lẻ xác định những ai có khả năng mua sản phẩm của họ. Ngành công nghiệp AI của Trung Quốc nổi bật hơn so với các đối thủ cạnh tranh khác nhờ khả năng hợp nhất sức mạnh kỹ thuật số và chuyên môn bán lẻ của họ thông qua việc tích hợp thành công dữ liệu trực tuyến, dữ liệu ngoại tuyến và hậu cần trong một chuỗi giá trị duy nhất.
Cùng với AI, sự tích hợp này đã cho phép tạo ra một mô hình phân phối siêu hiệu quả. Hồi tháng 5/2022, Baidu đã ra mắt taxi không người lái ở Bắc Kinh, trong khi đó công ty WeRide đã thực hiện hơn 150.000 chuyến đi ở Quảng Châu (đô thị 14 triệu dân) mà không để xảy ra một vụ tai nạn nào. Chắc chắn trong lĩnh vực AI tổng quát (một nhánh sử dụng nội dung hiện có để tạo ra nội dung mới), AI chatbot ChatGPT của Mỹ (có thể thực hiện những cuộc trò chuyện thông minh với người dùng) đã diễn ra một cuộc hành quân. Nhưng những gã khổng lồ của Trung Quốc đang sáng tạo không ngừng những ứng dụng mới và tìm cách cạnh tranh với những nền tảng của riêng họ.
Công cụ tạo hình ảnh hoạt hình Different Dimension Me của hãng Tencent đã trở thành một nền tảng mạng xã hội toàn cầu vào cuối năm 2022 khi nó có thể tạo ra những hình ảnh theo kiểu anime từ các bức ảnh khuôn mặt; và Baidu có mô hình 10 tỷ tham số (ERNIE-ViLG) đã trình làng vào giữa tháng 3/2023. Cũng không quên nhắc tới Idea (một phòng thí nghiệm nghiên cứu được dẫn đầu bởi nhà khoa học máy tính nổi tiếng Harry Shum) đã phát minh ra Taiyi – một mô hình chuyển văn bản thành hình ảnh quy mô lớn khác. Nhưng, bất chấp bối cảnh thuận lợi và nhiều sáng kiến đa dạng, Bộ trưởng Khoa học và Công nghệ Trung Quốc, ông Vương Chí Cương phải lên tiếng thừa nhận trong tháng 3/2023 rằng: “Trung Quốc phải đợi trước khi thấy kết quả” (so sánh với ChatGPT của Mỹ). Rõ ràng là AI của Trung Quốc ít được sử dụng trong đại dịch COVID-19, nó được sử dụng để hạn chế sự di chuyển của mọi người và dự báo sự phát triển của bệnh dịch, nhưng đóng vai trò rất nhỏ trong việc phát triển vaccine hiệu quả không giống như dự án Moderna của Mỹ.
Một số nhân tố giải thích cho sự thất bại của sáng kiến AI của chính phủ Trung Quốc. Trước tiên là, mặc dù 1/3 các nhà nghiên cứu AI giỏi nhất thế giới đến từ Trung Quốc nhưng chỉ có 1/10 trong số họ thực sự làm việc trên quê hương mình. Phần lớn nhân tài Trung Quốc đều lập nghiệp ở Mỹ, đến mức đây là “vũ khí bí mật về AI của Mỹ” - theo một nghiên cứu từ tổ chức tư duy MacroPolo của Mỹ. Ngoài tình trạng “chảy máu chất xám” này, còn có sự khác biệt giữa những khoản đầu tư được hứa hẹn và thực tế được chuyển giao, mà những nhân vật “máu mặt” trong ngành công nghiệp công nghệ thông tin (IT) của Trung Quốc đã công khai như một cách vận động tài trợ. Đó là trường hợp gói ngân sách 16 tỷ USD đến từ Thiên Tân (thành phố cảng lớn ở Đông Bắc Trung Quốc) vào năm 2018, không rõ liệu số tiền này khi nào thì được giải ngân, mà nếu có giải ngân thì liệu nó có trao đúng tay người nhận và dùng độc quyền cho AI hay không?
Bên trong Trung tâm máy tính AI của hãng SenseTime ở Thượng Hải (Trung Quốc). Ảnh nguồn: Analytics India magazine.
Quy định nghiêm ngặt của Bắc Kinh đối với lĩnh vực này cũng làm cản trở một số tiến bộ. Ant Group (cánh tay tài chính của Alibaba) đã bị đình chỉ niêm yết kép ở Hương Cảng và Thượng Hải vào tháng 11/2020, bị cụt cánh hoàn toàn. Những tay chơi trong ngành công nghiệp nếu vi phạm các quy tắc cạnh tranh sẽ bị phạt rất nặng. Hồi tháng 7/2022, sau một cuộc điều tra dài ngày, cơ quan quản lý mạng đã phạt Didi - “Uber của Trung Quốc” - số tiền 8 tỷ nhân dân tệ tương đương 1,16 tỷ USD. Năm 2021, 2 gã khổng lồ trò chơi máy tính là Tencent và NetEase đã bị phạt vì vi phạm luật chống độc quyền, họ bị cấm đưa những trò chơi mới ra thị trường cho đến cuối năm 2022, khiến giá cổ phiếu của 2 hãng này tụt dốc không phanh.
Cũng trong tháng 11 đó, một luật lớn về quyền riêng tư trực tuyến đã được thông qua bởi Đại hội đại biểu nhân dân toàn quốc có hiệu lực, và những tham số không chính xác của nó càng khiến các nhà điều hành xử lý dữ liệu người tiêu dùng gặp rủi ro cao hơn. Việc thắt chặt kiểm soát của Nhà nước cũng có thể làm làm mất động lực của những gã khổng lồ kỹ thuật số của Trung Quốc. Mặt khác, ngay đầu năm 2023, chính phủ Trung Quốc đột ngột đình chỉ kế hoạch đầu tư trị giá 148 tỷ USD cho ngành công nghiệp chất bán dẫn (bao gồm một số chương trình để hỗ trợ nghiên cứu và sản xuất chủ yếu thông qua trợ cấp và tín dụng thuế). Sự việc này vốn là hệ quả của cuộc điều tra chống tham nhũng đã hé lộ tên tuổi một số nhân vật hàng đầu, bao gồm Tiêu Á Khánh (nguyên Bộ trưởng Bộ công Nghiệp và Công nghệ thông tin Trung Quốc) và Đinh Văn Võ (người đứng đầu Quỹ Đầu tư công nghiệp mạch tích hợp Trung Quốc – CICIIF).
Washington đang đeo đuổi một lệnh cấm vận ngày càng nghiêm ngặt. Đầu tháng 10/2022, Nhà Trắng ban lệnh cấm các công ty Mỹ xuất thiết bị sản xuất chip sang Trung Quốc, vốn là thứ cần thiết cho máy tính hiệu suất cao và siêu máy tính, cũng như những con chip 14 nanomet và nhỏ hơn vốn là yêu cầu của các ngành công nghiệp công nghệ cao.
Trên thực tế lệnh cấm này còn bao gồm những công ty không phải của Mỹ đã làm hạn chế hơn nữa các lựa chọn của Bắc Kinh. Thậm chí Tổng thống Joe Biden còn giành chiến thắng ở Hà Lan, nơi có hãng ASML chuyên về các thiết bị sản xuất chip, và Nhật Bản nơi có 2 hãng Electron và Nikon. Tới tháng 1/2023, 3 nước Mỹ - Hà Lan – Nhật cùng ký kết một thỏa thuận hợp tác tiến tới tán thành lệnh cấm vận trên. Những hạn chế ngày càng tăng của chính quyền Mỹ đã làm tăng đáng kể sự chú ý của Trung Quốc đối với Đài Loan – quê hương của hãng sản xuất chất bán dẫn giá trị nhất thế giới: Hãng sản xuất chất bán dẫn Đài Loan (TSMC) – đơn vị đã sản xuất một nửa số chip tiên tiến trên thế giới. Những đòn trừng phạt này cũng siết chặt hơn một lĩnh vực đang bùng nổ ở Trung Quốc: vào năm 2020, nước này chiếm 9% thị trường chất bán dẫn toàn cầu (tổng doanh thu hàng năm đạt 39,8 tỷ USD) so với chỉ 3,8% vào năm 2015.
Nhưng Trung Quốc cũng chi khá tiền trong việc nhập khẩu những con chip tinh xảo (khoảng 378 tỷ USD hoặc 18% tổng kim ngạch nhập khẩu bao gồm cả năng lượng). Trung Quốc cũng sản xuất chất bán dẫn tốc độ chậm hơn được dùng trong máy tính và các thiết bị gia đình. Năm 2022, xuất khẩu của Trung Quốc giảm nghiêm trọng (giảm 72,8% so với năm 2021). Một số khách hàng nước ngoài có tâm lý lo sợ những hạn chế hơn nữa của chính quyền Mỹ nên giờ đây đang chọn cách đa dạng hóa chuỗi cung ứng của họ. Hãng Dell có kế hoạch ngừng sử dụng chip do Trung Quốc sản xuất vào năm 2024 và đã yêu cầu những nhà cung cấp của mình giảm số lượng các thành phần khác nhằm sản xuất ra chip. Đối thủ của Dell là Hewlett Packard cũng đang tìm hiểu các nhà cung ứng của mình nhằm đánh giá tính khả thi của việc di chuyển sản phẩm. Những gã khổng lồ công nghệ của Trung Quốc cũng đang từng bước bảo vệ lợi ích kinh doanh quốc tế của họ. Movio (tên cũ là Surreal) chuyên sản xuất nền tảng video AI cho video tiếp thị đã chuyển trụ sở đến Los Angeles và bán các dịch vụ trên thị trường toàn cầu bất chấp thành công rực rỡ của họ tại Trung Quốc trong thời điểm đại dịch COVID-19.
Hiện thời ngành công nghiệp Trung Quốc vẫn có trữ lượng đáng kể chất bán dẫn trong các phòng thí nghiệm Nhà nước và tư nhân. Nhưng về lâu dài sự thiếu hụt có thể đe dọa khả năng tạo ra những thuật toán mạnh mẽ của riêng nó, vốn rất quan trọng đối với cạnh tranh AI. Điều này có thể ảnh hưởng tới những công ty có sử dụng phần cứng của Mỹ đặc biệt là những phương tiện tự chủ và hậu cần cũng như các trung tâm nghiên cứu dùng AI để khám phá thuốc. Đang có một số ủng hộ đầu tư cao hơn nữa để thu hẹp khoảng cách, người ta đang nói về kế hoạch giải ngân 145 tỷ USD. Điều chắc chắn nhấn mạnh là phát triển AI vẫn được duy trì: ông Tập Cận Bình đã đề cập đến AI tới 40 lần trong báo cáo của mình trước Đại hội đại biểu toàn quốc Đảng Cộng sản Trung Quốc lần thứ 20 vào tháng 10/2022. Thái độ của Washington có thể sẽ khiến Bắc Kinh tự tách mình với phần còn lại của thế giới và dẫn đến những tiêu chuẩn kỹ thuật khác nhau gây cản trở tiềm năng hợp tác toàn cầu về công nghệ mới.
Việc chàng trai 24 tuổi sử dụng AI để “hồi sinh” người bà quá cố đã dấy lên cuộc tranh luận của cư dân mạng về vấn đề ứng dụng công nghệ mới trong lĩnh vực này.
Nguồn: [Link nguồn]